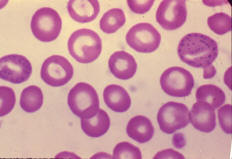

El plomo es uno de muchos metales que pueden ser flexibles y muy pesados a la vez; es por eso que se puede usar de muchas formas. Es decir, que el plomo es muy fundamental en nuestras vidas, porque debido a su propósito, podemos tener muchas cosas de vital importancia en nuestro alrededor.
Él es un componente químico que conforma la tabla periódica, su número atómico correspondiente es 82 y su símbolo es Pb; la palabra plomo llega del latín Plumbum. El plomo pertenece al conjunto de los elementos metálicos. Y procedente de muchas utilidades, tanto en industrias y como en muchas empresas químicas.
Tabla de Contenidos
Características del plomo
 Este tipo de metal tiene un color gris oscuro y también un poco de azul claro; igualmente, tienen una forma nativa sólida. Asimismo, está compuesta con varios metales que le da una dureza magnifica; puede que la resistencia del consumo atmosférico y a las agresiones de los ácidos que hace que sea demasiado útil.
Este tipo de metal tiene un color gris oscuro y también un poco de azul claro; igualmente, tienen una forma nativa sólida. Asimismo, está compuesta con varios metales que le da una dureza magnifica; puede que la resistencia del consumo atmosférico y a las agresiones de los ácidos que hace que sea demasiado útil.
Propiedades físicas
- Solidez (g/cm3): 11,342
- Punto de fundición (°C): 328
- Volumen nuclear (cm3/mol): 18,27
- Tonalidad: Blanco azulado
- Punto de ebullición (°C): 1749
Propiedades periódicas
- Disposición electrónica: [Xe] 4f14 5d10 6s2 6p2
- Radio iónico (Å): 0,84 (+4), 1,20 (+2)
- Energía de ionización (kJ/mol): 716
- Afinidad electrónica (kJ/mol): 35
- Radio atómico (Å): 1,75
- Radio covalente (Å): 1,47
- Electronegatividad: 2,33
¿Para qué sirve el plomo?
El plomo te puede servir de mucha ayuda, ya que eternamente vamos a estar utilizando este metal en nuestro círculo de vida. Es muy necesario, porque con él se pueden hacer muchas cosas, tales como: los cables eléctricos, las pinturas, los pigmentos y también materiales de construcción relacionados con la fontanería.
Es decir, en cada una de nuestras casas siempre vamos a estar necesitando dichos materiales que están relacionados con el plomo; porque con él es que tenemos electricidad, también podemos tener el abastecimiento de agua potable, lo cual es de vital importancia; igualmente la pintura, que es necesaria para que los lugares se vean llamativos y muy alegres. El plomo nos puede brindar estas cosas y muchas más.
¿Quién inventó el plomo?
El inventor del plomo fue Thomas Midgley, el cual fue un químico e ingeniero; y dedicó toda su vida en la ingeniería mecánica, ya que le gustaba mucho esta carrera y siempre destacó en ella.
Él fue uno de los ingenieros químicos de estados unidos, más reconocidos por su magnífica inteligencia que demostró al descubrir la gravedad que causaba el plomo en la gasolina; eso era una grave ocurrencia porque fue allí donde se desbordó una gran parte de químicos que pudo afectar el medio ambiente por varios años.
¿Para qué compran el plomo?
El plomo lo compran para poder hacer varios objetos, que son muy importante para el uso diario de nuestro alrededor. Es decir, que la mayor parte de los que compran este metal son herreros; y es vital su compra, para poder realizar todo tipo de pieza.
También hay personas que compran plomo reciclaje para poder reutilizarlo y hacer muchas cosas con él; su compra puede que sea más barata. Ya que, debido a eso pueden fundirlo y poder hacer cosas que tengan mucho valor; y su venta sea la apropiada para los clientes.
 ¿Qué enfermedad produce el plomo?
¿Qué enfermedad produce el plomo?
Este metal puede que cause muchas enfermedades, tales como el «saturnismo o plumbismo», los cuales son los más graves que puede haber por parte de este metal. Es decir, que estas enfermedades pueden causar varios malestares que pueden llegar hacer demasiado catastrófico y hasta puede causar la muerte.
Muchos de los síntomas son: Insomnio, convulsiones, letargo, vómitos, dolor de cabeza, psicosis, hiperactividad y vértigo. Por lo tanto, podemos ver que hay muchas enfermedades causadas por el plomo, las cuales puede ser muy malignas para el ser humano; y es por eso que se recomienda tener más cuidado con lo que comemos y bebemos. Ya que la mayor parte de estos padecimientos los encontramos en las bebidas y en las comidas; las cuales son: carne, crustáceos, granos, frutas, hortalizas, gaseosas, vino y agua potable.
Deberían de tomar en cuenta que estos tipos de comida y líquidos, son muy dañina para la salud del ser humano, porque por ellos podemos llegar a tener una fuerte enfermedad y llevarnos hasta la muerte; es por eso que no se recomienda mucho estos tipos de alimentos.
¿Cuándo se descubrió?
El plomo fue uno de los metales que se descubrió en la época de la prehistoria; es el doceno en la tabla periódica por orden de descubrimiento. Por tanto, fue uno de los primeros en encontrarse y es por eso que su utilidad es muy reconocida hoy en día.
Con exactitud en la actualidad no se ha podido determinar cuándo fue la fecha exacta que se descubrió este elemento químico. Se puede decir que los hebreos lo conocían, porque en la biblia relata en los libros de éxodos, que en aquel tiempo los habitantes de dicha nación lo usaba como conducción de agua y en otras labores diarias.
¿Cómo se extrae?
 Este tipo de metal se extrae de las minas, se puede encontrar en muchos metales; es decir, el plomo se extrae de otros metales, puede que haya más de 60 metales que tengan plomo. Este metal mayormente se encuentra en otros metales; por lo tanto que no se puede hallar en su estado básico.
Este tipo de metal se extrae de las minas, se puede encontrar en muchos metales; es decir, el plomo se extrae de otros metales, puede que haya más de 60 metales que tengan plomo. Este metal mayormente se encuentra en otros metales; por lo tanto que no se puede hallar en su estado básico.
Principalmente su mayor porción se encuentra extraído de un metal llamado galena. Ya que, ese metal está compuesto por un gran porcentaje más asimilado al plomo, que al de sulfuro. Es decir, la galena es la fuente principal de extracción del plomo, y su otra parte que vendría siendo muy poco, es de sulfuro. La cual hace a este metal muy fundamental.
¿Por qué el plomo contamina al medio ambiente?
El plomo aunque es altamente tóxico, está presente en muchas industrias; para ser aplicado en la distribución de las municiones de armas de fuego, para la pasivación de metales. También, en las explotaciones mineras y en fabricaciones específicas.
Por esa razón es que este elemento puede que cause mucho desastre en la atmósfera, por su integración a la humanidad. Es decir, que su uso es muy importante; pero también como es significativo, tiene su defecto, el cual es la contaminación en el medio ambiente.
También te podría interesar el siguiente artículo: carbono.
¿Qué enfermedad produce el plomo?
¿Qué enfermedad produce el plomo?
Deja una respuesta